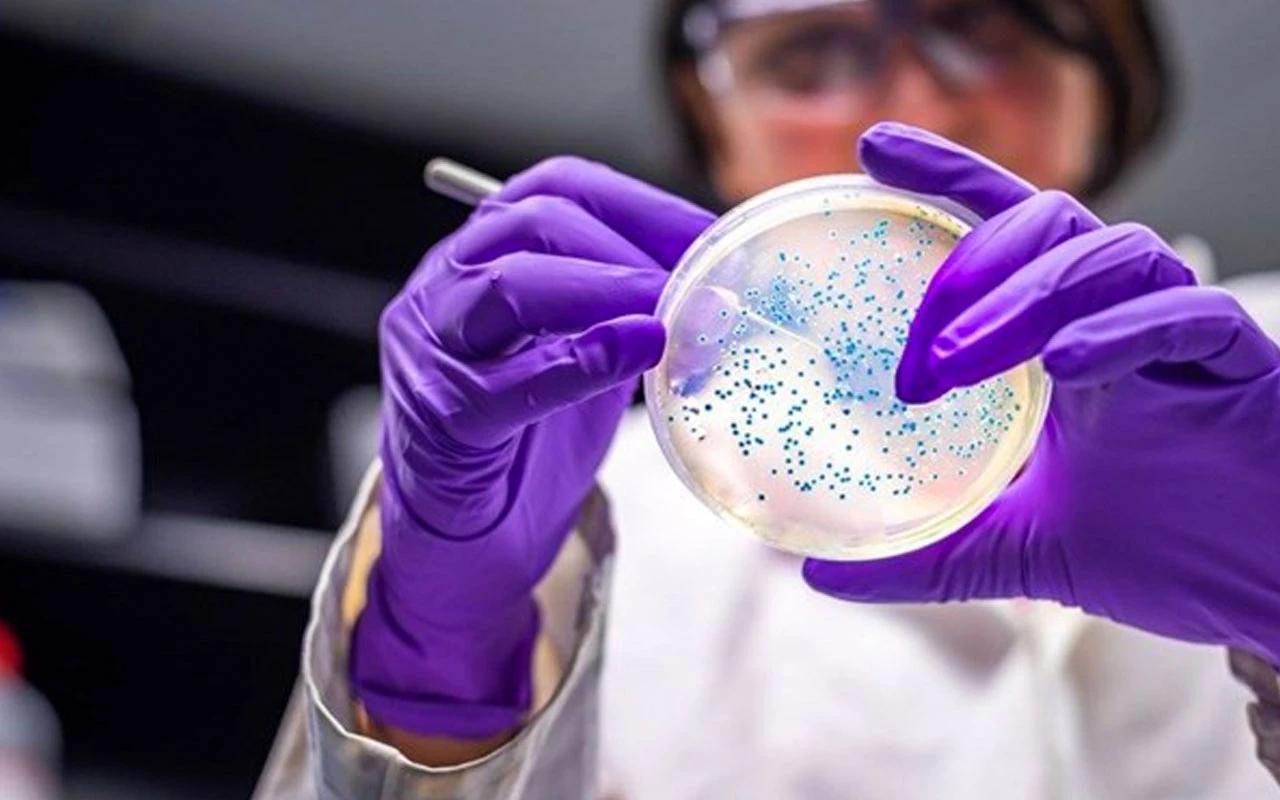
Mūsu apsēstības ar Marsa terraformēšanu gaitā mēs atklājām divas baktērijas: viena ražo cementu, otra to aizsargā.

Marss ir kļuvis par īstu apsēstību. Misijas, kas līdzīgas SpaceX vadītajai, to apstiprina, un, godīgi sakot, nokļūt tur ir “vieglā” daļa. Patiesi grūti ir terrafomēt planētu, lai nodrošinātu ilgstošas misijas uz tās virsmas. Filmā „Marsietis” mēs redzējām astronautu, kurš izdzīvo uz Marsa, barojoties ar kartupeļiem, kas audzēti uz tā virsmas, un, lai gan tas var šķist zinātniskā fantastika, mēs jau sasniedzam progresu šajā jomā. Bet mums ir arī jābūvē, un labākais veids, kā to izdarīt, ir izmantot Marsa putekļus, lai izgatavotu ķieģeļus.
Biofonds. Gan Mēness, gan Marss ir klāti ar putekļiem. Šie putekļi sastāv no vairākiem elementiem, kurus mēs varam izmantot savā labā, lai radītu celtniecības materiālus. Daudz vieglāk ir izdomāt veidus, kā pārvērst šos materiālus kaut kas noderīgā, nekā transportēt kilogramus materiālu no Zemes, un pētījumā, kas publicēts žurnālā Frontiers in Microbiology, tiek apskatīta šī problēma.
Tajā pētnieki no Milānas Politehniskā universitātes Džūlio Nata ķīmijas, materiālu zinātnes un ķīmijas inženierijas katedras apraksta procesu, kā pārvērst Marsa regolitu par betona līdzīgu materiālu, izmantojot procesu, ko sauc par biocementāciju. Viņi ierosina izmantot divas baktērijas, kas spēj veikt šo pārveidošanu.
Baktērijas-«mūrnieki» . Galvenie dalībnieki ir Sporosarcina pasteurii un Choococcidiopsis , bet galvenais tehnoloģijas process ir «mikrobiāli inducēta kalcija karbonāta nogulsnēšanās»: process, kurā mikroorganismi istabas temperatūrā rada kalcija karbonātu. Sporosarcina pasteurii gadījumā šis process balstās uz ureolīzi.
Tādējādi baktērijas ražo fermentu ureāzi, kas hidrolizē urīnvielu līdz amonjakam un ogļskābei. Atbrīvojoties, tas paaugstina vides pH, bet ogļskābe disociējas uz karbonāta joniem. Savienojoties ar vidē esošajiem kalcija joniem, tie nogulsnējas kā kalcija karbonāta kristāli uz baktēriju šūnu sienām un augsnes daļiņām.
Sarežģīts un tehnisks izskaidrojums ir tāds, ka tie rada nogulsnes, kas darbojas kā dabīgs cements, saistot Marso regolitā esošās daļiņas un pārvēršot dabīgi irdeno putekļus kompaktiem materiāliem ar tādu pašu spiedes izturību kā dažiem betona maisījumiem.
BIOMEX . No otras puses, ir Choococcidiopsis . Tas ir viens no izturīgākajiem organismiem, kas mums ir zināms, līdzīgi draudzīgajiem lēnīšiem. Tie spēj izdzīvot apstākļos, kas imitē Marsa vidi. Pirms dažiem gadiem Eiropas Kosmosa aģentūras misija BIOMEX parādīja, ka šīs baktērijas celmi, kas 18 mēnešus bez jebkādas aizsardzības bija pakļauti gan kosmiskajam vakuumam, gan saules starojumam, palika neskarti. Pēc rehidratācijas tie atsāka savu metabolisko aktivitāti.
Tas ir svarīgi, jo mēs jau esam “izmēģinājuši” Choococcidiopsis kosmosā, un tās loma šajā stāstā ir saistīta nevis ar tās spēju pārvērst regolītu betonā (šo funkciju veic cita baktērija), bet gan ar tās izcilo izturību. Pētnieki ierosina sadarbību starp abām baktērijām.
Aizsardzības arsenāls . Tas nozīmē, ka, kamēr viena darbojas, otra nodrošina barošanu un aizsardzību. Un patiesi, Choococcidiopsis aizsardzības arsenāls ir iespaidīgs. Līdzīgi kā mūsdienu tanku bruņai, tam ir trīs aizsardzības līnijas:
- Pirmā sastāv no ārpusšūnu polimēru vielām, kas veido biezu slāni, kas filtrē gandrīz 70 % UVA starojuma, gandrīz 70 % UVM starojuma un gandrīz 90 % UVC starojuma.
- Otrā līnija sastāv no antioksidantiem, kas saistās ar ārējo membrānu un darbojas kā fotoprotektori, neitralizējot aktīvās skābekļa formas, kas veidojas radiācijas ietekmē.
- Trešā aizsardzība ietver UV filtrus. Turklāt Choococcidiopsis spēj atjaunot savu DNS, kas bojāta radiācijas ietekmē.
Papildus būvniecībai . Tas ir izturīgs un stabils, bet, pirms mēs aizraujamies un nosūtām baktērijas uz Marsu, pati komanda paskaidro, ka mums jārīkojas pakāpeniski. Lai gan dažādas aģentūras vēlas uzbūvēt pirmo cilvēka dzīves vidi uz Marsa līdz 2040. gadam, problēma vairs nav tikai būvniecība uz planētas: mums ir precīzi jāatbild uz jautājumu, kā šie pionieri atgriezīsies.
Pašlaik viņi demonstrē, ka Marsa materiālus var pārvērst celtniecības materiālos, bet vēl ir garš ceļš ejams, piemēram, Marsa apstākļu atjaunošana uz Zemes, lai optimizētu celtniecības procesus. Atklājumi, kas līdzīgi šo baktēriju kopīgajam darbam, var novest ne tikai pie jaunu būvniecības tehnoloģiju parādīšanās, bet arī pie dažu baktēriju potenciālās izmantošanas skābekļa ražošanai uz Marsa vai pat to atkritumu izmantošanai kā barotni kosmosā.





